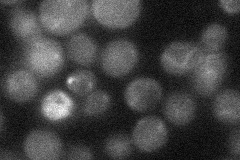
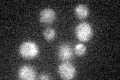

View description
Multifunctional enzyme of the folic acid biosynthesis pathway, has dihydropteroate synthetase, dihydro-6-hydroxymethylpterin pyrophosphokinase, and dihydroneopterin aldolase activities
Localization:
Intensity:
Fold change:
Significance:
-
C’ GFP library in SD

below threshold15.66 -
N' NOP1pr-GFP in SD

cytosol123.221 -
N' TEF2pr-mCherry in SD

cell periphery,vacuole126.048 -
N' NATIVEpr-GFP in SD
cytosol25.9531 -
N' TEF2pr-VC and Cyto-VN in SD

#N/A0 -
C’ GFP library in SD+DTT

cytosol17.141.09No -
C’ GFP library in SD+H2O2
cytosol15.841.01No -
C’ GFP library in Starvation Media

cytosol171.08No -
C’ GFP library on the background of Pup2-DaMP

below threshold -
C’ GFP library on the background of CCT mutant

below threshold16.22481.03557No
